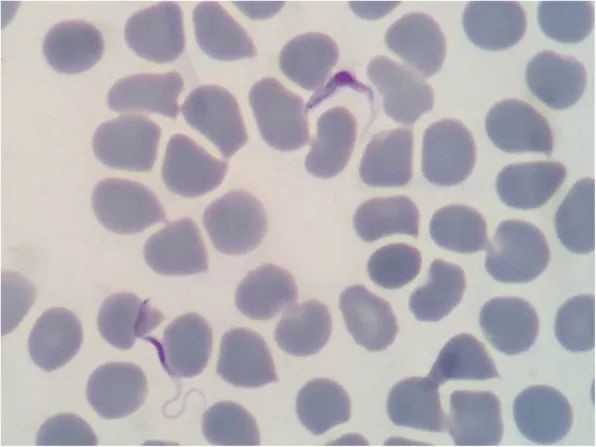

- taptap的下载官网taptap国际服怎么正常使用(国家热带病研究中心)2025年优秀大学生夏令营活动招收简章
- 中国疾控中心寄生虫病所2025年第二批博士生招生考试一志愿初审进入复试人员名单公示
- 2025年度国家卫生健康委寄生虫病原与媒介生物学重点实验室开放课题申请通知
- 中国疾控中心寄生虫病所(国家热带病研究中心)2025年部门预算
- 中国疾控中心寄生虫病所2025年博士研究生招生调剂信息公布
- 中疾控寄生虫病所(国家热带病研究中心)2025年招生简介
- 中国疾控中心寄生虫病所(国家热带病研究中心)2025年度招聘人员公告
- taptap的下载官网taptap国际服怎么正常使用(国家热带病研究中心)2023年度部门决算
2017年8月,taptap的下载官网taptap国际服怎么正常使用(国家热带病研究中心)接报了一例从非洲旅游归国的不明原因发热病例,该患者就诊于福建医科大学附属协和医院,福建省疾病预防控制中心病原学检测初步判断为锥虫病,taptap的下载官网taptap国际服怎么正常使用复核确认为我国首例罗得西亚非洲锥虫病并开展联合处置工作。该患者于7月23日至8月5日在非洲肯尼亚和坦桑尼亚旅游,7月28日在坦桑尼亚的赛伦盖蒂国家公园大草原中有被“牛苍蝇” 叮咬史,8月6日回国后发现右脚后跟(叮咬部位)有一暗红色包块,中央有破溃,周围略肿胀,有压痛,质地较软,8月8日起持续性高热。根据流行病学史、临床表现以及实验室检查等结果8月14日被确诊为布氏锥虫罗得西亚亚种感染引起的非洲锥虫病(如图1)。
下面我们详细了解一下非洲锥虫病
1.什么是非洲锥虫病?
非洲锥虫病,又称昏睡病,经舌蝇(Glossina spp.,俗称采采蝇tsetse fly)叮咬人体引起布氏锥虫感染的原虫病。根据感染布氏锥虫亚种的不同可分为冈比亚锥虫病和罗得西亚锥虫病。病原体侵入人体主要侵袭中枢神经系统,出现昏睡等症状,流行于非洲国家。
冈比亚锥虫病,由布氏锥虫冈比亚亚种感染引起的一种病程发展缓慢的锥虫病。主要流行于非洲中部和西部。
罗得西亚锥虫病,由布氏锥虫罗得西亚亚种感染引起的一种起病急、病程发展迅速的锥虫病。主要流行于非洲东部和南部。
2.人是怎么感染布氏锥虫的?
经舌蝇(如图2)叮咬、母婴垂直传播、输血或器官移植等途径均可感染布氏锥虫。

图2. 布氏锥虫媒介——舌蝇(采采蝇)
(图片引自Vector control and the elimination of gambiense human African trypanosomiasis (HAT) – Joint FAO/WHO Virtual Expert Meeting, 5–6 October 2021)
3.人得了非洲锥虫病有哪些症状?
发热、头痛、瘙痒、肌肉疼痛、骨骼疼痛、表情淡漠、共济失调、嗜睡和昏睡等症状,锥虫下疳(gān)(如图3)、淋巴结肿大、肝脾肿大等体征。其中,冈比亚锥虫病发病进程慢,而罗得西亚锥虫病发病进程快。

图3. 锥虫下疳
4.如何诊断非洲锥虫病?
一是询问病人有无非洲疫区旅居史、舌蝇叮咬史、输血或器官移植史。
二是查看病人有无发热、头痛、瘙痒、肌肉疼痛、骨骼疼痛、表情淡漠、共济失调、嗜睡和昏睡等症状,锥虫下疳、淋巴结肿大、肝脾肿大等体征。
三是实验室检查病人血清中布氏锥虫抗体是否阳性,病人血液、淋巴液、下疳抽吸液、骨髓穿刺液或脑脊液镜检中是否查见布氏锥虫锥鞭毛体(如图4),或布氏锥虫核酸检测阳性。

图4. 吉氏染色薄血膜涂片中的布氏锥虫锥鞭毛体(1000×)
(图片引自https://www.cdc.gov)
5.如何防治非洲锥虫病?
一是做好卫生宣教
加强对援非、赴非务工人员及赴非旅游人员进行包括非洲锥虫病等在内的热带病防治知识健康教育,提高公众自我防护意识,防止感染。二是做好检测和监测
加强对援非、赴非务工人员、赴非旅游人员和非洲国家入境人员的非洲锥虫病检测和监测工作,做到早发现、早诊断可能病例。
三是做好诊断试剂及治疗药物储备
非洲锥虫病治疗药物包括苏拉明钠(Suramin sodium)、戊烷脒(Pentamidine)依氟鸟氨酸(Eflornithine)和美拉胂醇(Melarsoprol)等,建议有条件的地区开展非洲锥虫病的病原学诊断、治疗技术储备。
图片仅供科普宣传使用,若有不当,请联系删除。
作者:陈木新 、蔡玉春
审核:卢艳、许学年
编辑:蔡玉春、周丹丹
